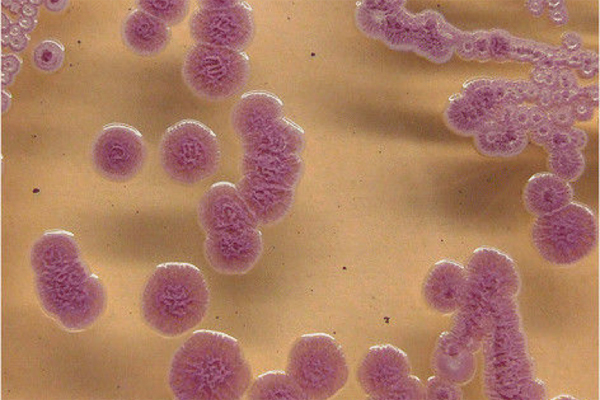
{keywords}

BS Phạm Văn Hà, khoa Nhi, Bệnh viện đa khoa Hùng Vương, Phú Thọ cho biết, bệnh nhi 11 tháng được gia đình đưa vào viện do sốt cao ngày thứ 7 kèm rét run.
Trước đó, cháu bé đã điều trị tại bệnh viện huyện 5 ngày nhưng không hạ sốt, trẻ ho đờm nhiều, thở khò khè.
Sau khi xét nghiệm máu, chụp X-quang, trẻ được chẩn đoán nhiễm khuẩn huyết, áp xe phổi. Kết quả cấy máu sau 3 ngày khẳng định bệnh nhi dương tính với vi khuẩn Whitmore.
Nhận thấy trẻ trong tình trạng nặng, các bác sĩ khoa Nhi đã trao đổi với chuyên gia của Bệnh viện Nhi Trung ương, thống nhất chuyển bệnh nhi xuống Hà Nội để tiếp tục phẫu thuật ngoại khoa, dẫn lưu mủ trong phổi, dùng kháng sinh...
Vi khuẩn Whitmore dưới kính hiển vi
Theo BS Hà, đến nay vẫn chưa xác định được nguồn nhiễm Whitmore với trường hợp bệnh nhi nói trên.
Bệnh melioidosis còn được gọi là bệnh Whitmore, là một bệnh truyền nhiễm cấp tính nguy hiểm do vi khuẩn gram âm Burkholderia pseudomallei gây ra. Căn bệnh này được phát hiện đầu tiên trên thế giới vào năm 1911.
Vi khuẩn B. pseudomallei sống trong bùn đất và nước, lây truyền cho người và động vật chủ yếu qua vùng da trầy xước do tiếp xúc với vi khuẩn hoặc hít phải các hạt bụi đất chứa vi khuẩn.
Dù là vi khuẩn nguy hiểm, song GS Nguyễn Văn Kính, Chủ tịch Hội Truyền nhiễm Việt Nam cho biết, bệnh Whitmore không gây ra dịch và không lây truyền từ người sang người.
“Bản chất của vi khuẩn Whitmore gây ra các ca bệnh tản phát nhưng dẫn tới những bệnh cảnh lâm sàng rất nặng nề. Đơn cử như nhiễm trùng huyết, tổn thương tại chỗ, đặc biệt là tổn thương vào phổi - virus này gây ra tổn thương ở phổi giống như là tụ cầu, của bệnh lao nên dễ bị chẩn đoán nhầm”, GS Kính thông tin.
Tuy nhiên, ngay cả khi được khẳng định mắc Whitmore, việc điều trị cũng hết sức khó khăn vì phải dùng kháng sinh tấn công liều cao kéo dài liên tục trong ít nhất khoảng 2 tuần, sau đó dùng tiếp kháng sinh duy trì trong 3-6 tháng.
Nếu không được điều trị đúng liều, đúng phác đồ và theo dõi sát sao, bệnh dễ tái phát, sức khỏe suy kiệt dần và vẫn có thể tử vong dù đã được chẩn đoán đúng. Việc theo dõi điều trị bệnh kéo dài, lại tốn kém nên không ít bệnh nhân đã bỏ cuộc. Đây cũng là 1 trong là những nguyên nhân dẫn đến thất bại trong điều trị và tỷ lệ tử vong do Whitmore còn cao, có thể lên tới 40%.
Các chuyên gia khuyến cáo, Whitmore hiện chưa có vaccine phòng bệnh, việc phòng ngừa hiện nay vẫn chủ yếu ở thói quen của người dân. Người dân cần hạn chế tiếp xúc nước bẩn, đất khi trầy xước da. Khi bị thương cần rửa sạch, sát trùng vết thương. Mọi người hạn chế tới những nơi nghi có nguồn bệnh; thực hiện ăn chín, uống sôi.
Thúy Hạnh

Người đàn ông nguy kịch chỉ sau 1 vết xước do căn bệnh bị lãng quên
Chỉ từ một vết xước ở đùi, dần dần hình thành ổ áp xe lớn, ăn vào xương khiến bệnh nhân nhiễm khuẩn huyết nặng, phải thở oxy.